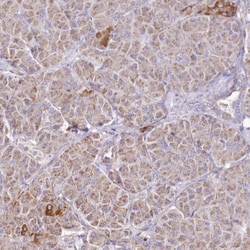
Invitrogen HADHB Polyclonal Antibody 100 &mu;L | Buy Online | Invitrogen&trade; | Fisher Scientific

missing translation for 'onlineSavingsMsg'
Learn More
Learn More
Invitrogen™ HADHB Polyclonal Antibody


Description
Immunogen sequence: GTVIQEVKTS NVAREAALGA GFSDKTPAHT VTMACISANQ AMTTGVGLIA SGQCDVIVAG GVELMSDVPI RHSRKMRKLM LDLNKAKSMG QR Highest antigen sequence indentity to the following orthologs: Rat - 91%, Mouse - 92%.
This gene encodes the beta subunit of the mitochondrial trifunctional protein, which catalyzes the last three steps of mitochondrial beta-oxidation of long chain fatty acids. The mitochondrial membrane-bound heterocomplex is composed of four alpha and four beta subunits, with the beta subunit catalyzing the 3-ketoacyl-CoA thiolase activity. The encoded protein can also bind RNA and decreases the stability of some mRNAs. The genes of the alpha and beta subunits of the mitochondrial trifunctional protein are located adjacent to each other in the human genome in a head-to-head orientation. Mutations in this gene result in trifunctional protein deficiency. Alternatively spliced transcript variants encoding different isoforms have been described.

Specifications
Specifications
| Antigen | HADHB |
| Applications | Immunohistochemistry (Paraffin), Western Blot |
| Classification | Polyclonal |
| Concentration | 0.1 mg/mL |
| Conjugate | Unconjugated |
| Formulation | PBS with 40% glycerol and 0.02% sodium azide; pH 7.2 |
| Gene | HADHB |
| Gene Accession No. | P55084 |
| Gene Alias | 2-enoyl-Coenzyme A (CoA) hydratase, beta subunit; 3-ketoacyl-CoA thiolase; 3-ketoacyl-Coenzyme A (CoA) thiolase of mitochondrial trifunctional protein, beta subunit; 4930479F15Rik; acetyl-CoA acyltransferase; bet; Beta-ketothiolase; ECHB; HADHB; hydroxyacyl-Co; hydroxyacyl-CoA dehydrogenase/3-ketoacyl-CoA thiolase/enoyl-CoA hydratase (trifunctional protein), beta subunit; hydroxyacyl-Coenzyme A dehydrogenase/3-ketoacyl-Coenzyme A thiolase/enoyl-Coenzyme A hydratase (trifunctional protein), beta aubunit; hydroxyacyl-Coenzyme A dehydrogenase/3-ketoacyl-Coenzyme A thiolase/enoyl-Coenzyme A hydratase (trifunctional protein), beta subunit; mitochondrial trifunctional protein, beta subunit; MSTP029; MTPB; TP-BETA; trifunctional enzyme subunit beta, mitochondrial |
| Gene Symbols | HADHB |
| Show More |
Product Title
By clicking Submit, you acknowledge that you may be contacted by Fisher Scientific in regards to the feedback you have provided in this form. We will not share your information for any other purposes. All contact information provided shall also be maintained in accordance with our Privacy Policy.
Spot an opportunity for improvement?